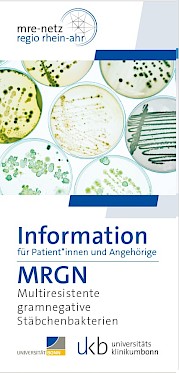
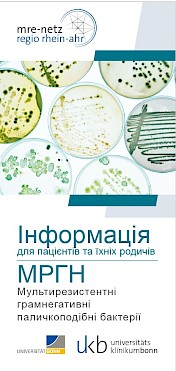
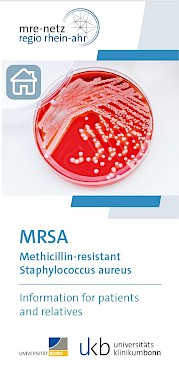
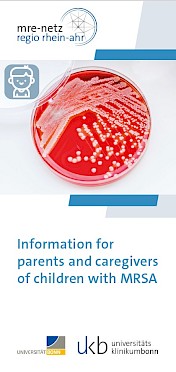
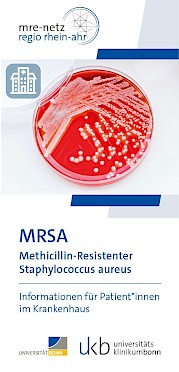
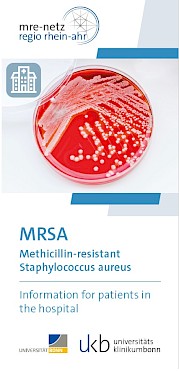

Flyer des mre-netz regio rhein-ahr
Hier können Sie die vom mre-netz regio rhein-ahr zur Verfügung gestellten Flyer herunterladen. Die Flyer sind in drei Kategorien eingeteilt, die sie durch herunterscrollen weiter unten auf der Seite finden.
Einrichtungen haben das Nutzungsrecht für alle Flyer in unveränderter Form und ausschließlich für nicht-kommerzielle Zwecke. Die Kontaktseite der Flyer kann mit dem eigenen Einrichtungslogo und Kontaktinformationen angepasst werden. Bei Fragen zu den Flyern oder wenn sie gedruckte Exemplare benötigen, melden Sie sich bitte beim mre-netz.
To have the flyers translated into other languages, click here.
Pour faire traduire les dépliants dans d'autres langues, cliquez ici.
litarjamat almanshurat 'iilaa lughat 'ukhraa, anqur huna.
Chtoby perevesti listovki na drugiye yazyki, nazhmite zdes'.
Shchob pereklasty flayery inshymy movamy, natysnitʹ tut.
Broşürlerin diğer dillere çevrilmesini istiyorsanız buraya tıklayın.
Flyer-Serie "Informationen für Patienten und Angehörige":
Hände- und Basishygiene - Deutsch

Händehygiene und Basishygiene- im Krankenhaus und Zuhause
Hände- und Basishygiene - Englisch

Hand hygiene and basic hygiene - at the hospital and at home
MRGN - Deutsch
MRGN- Umgang mit den Erregern MRGN Zuhause, in Pflegeeinrichtungen und im Krankenhaus
MRGN - Englisch

MRGN- Dealing with the pathogens MRGN at home, in care facilities and at hospitals
MRGN - Ukrainisch
MRGN- Borotʹba z patohenamy MRGN vdoma, v ustanovakh dohlyadu ta likarnyakh
Clostridioides difficile

C. diff./Clostridioides difficile- Durchfall infolge Antibiotikabehandlung
VRE- Informationen für Patienten und Angehörige - Deutsch

VRE- Informationen für Patient*innen und Anghörige
VRE- Informationen für Patienten und Angehörige - Englisch

VRE- Information for patients and relatives
Flyer-Serie MRSA:
MRSA - Informationen für Patienten und Angehörige - Deutsch

MRSA- Informationen für Patienten und Angehörige
MRSA - Informationen für Patienten und Angehörige - Englisch
MRSA- Information for patients and relatives
MRSA - Informationen für Eltern und Betreuer von Kindern mit MRSA - Deutsch

MRSA- Informationen für Eltern und Betreuer von Kindern mit MRSA
MRSA - Informationen für Eltern und Betreuer von Kindern mit MRSA - Englisch
MRSA- Information for parents and caregivers of children with MRSA
MRSA - Informationen für Patienten im Krankenhaus - Deutsch
MRSA- Informationen für Patient*innen im Krankenhaus
MRSA - Informationen für Patienten im Krankenhaus - Englisch
MRSA- Information for patients in the hospital
Flyer-Serie "Antibiotika verantwortungsvoll einsetzen - Machen Sie mit!":
Atemwegserkrankungen

Atemwegserkrankungen- "Weniger ist mehr" bei Erwachsenen, gilt auch für Kinder
Ohrenschmerzen

Ohrenschmerzen- "Wenn möglich, ohne" bei Kindern, gilt auch für Erwachsene
Harnwegsinfektionen

Harnwegsinfektionen- "Wenn dann richtig"
Hinweis: Bei den fremdsprachlichen Übersetzungen wurde ein automatisiertes Übersetzungstool (z. B. Google Translate / KI) verwendet. Die Übersetzung erfolgte nach bestem Wissen und Gewissen, jedoch ausdrücklich ohne Gewähr für die Richtigkeit. Eine Haftung für die Richtigkeit, Vollständigkeit oder Aktualität der Übersetzung wird daher ausdrücklich ausgeschlossen.














